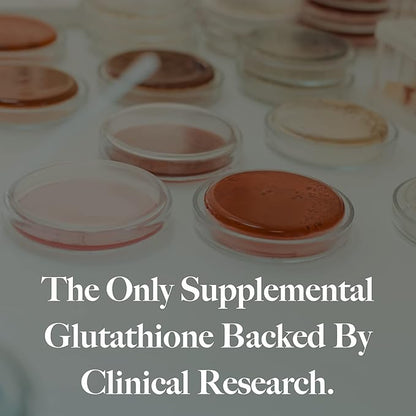

UtzyNaturals
L-Glutathione | Immune Health & Antioxidant Support | Setria® 250mg Reduced Form Glutathione | High Absorption | Made in The USA | 60 Capsules
L-Glutathione | Immune Health & Antioxidant Support | Setria® 250mg Reduced Form Glutathione | High Absorption | Made in The USA | 60 Capsules
Couldn't load pickup availability
About This
- Supports Immune Health: Formulated with Setria L-Glutathione to help maintain a healthy immune system.
- Antioxidant Protection: Provides antioxidant support to help protect cells from oxidative stress. Helps support natural cellular processes by maintaining healthy glutathione levels.
- Clinically Studied Ingredient: Utilizes Setria, a unique tri-peptide form of glutathione shown to increase blood levels when taken orally.
- Clean and Allergen-Friendly: Free from gluten, corn, yeast, artificial colors, and flavors, making it suitable for various dietary needs. Made through a fermentation process that supports a clean, plant-based formula.
- Quality Assurance: Backed by Utzy's 90-day Empty Bottle Guarantee, ensuring customer satisfaction.
Overview
- Brand : Utzy Naturals
- Flavor : Unflavored
- Primary Supplement Type : L-Glutathione
- Unit Count : 60 Count
- Item Form : Capsule
- Item Weight : 0.17 Kilograms
- Item dimensions L x W x H : 7.32 x 5.83 x 2.44 inches
- Special Ingredients : Setria
- Diet Type : Gluten Free
- Product Benefits : Antioxidant,Detox
Share







Let customers speak for us
from 100 reviewsI’ve been taking Centrum Multivitamin for Women daily for a few months, and overall I’m pleased with the results. Formulated specifically for women, it contains 23 essential nutrients—including iron, biotin, vitamin D₃, calcium, B-complex, vitamin C/E, and zinc—to help support energy levels, immunity, hair/nail health, and bone strength .
The hubby and I take this Naturelo daily vitamin. We started 2 months ago and just reordered. We both see our hair and nails growing better. Naturelo daily vitamin has everything you need in just one capsule a day. We have not been sick since starting this product. Also i take we both take the mens daily vitamin. The womens vitamin has iron in it and I do not need that. I would recommend this product.
A friend had already bought it before, recommended it to me, and I made the purchase, and I don't regret it. I bought it for my dad, and this vitamin supplement has been very useful.
I’ve been taking these multivitamins for 3 months now and will continue because they seem to be true to what they advertise. I haven’t been sick, have had 0 UTI’s and feel that my energy levels are normal. This was not the case with other women’s multivitamins. My Mother in Law who had MS takes them too because that’s what her doctor recommended.
Have taken for many years. they are on the larger side and have a strong taste so be warned. I don’t mind either of those. They do well on an empty stomach too. I think the quality is overall great.
Estas vitaminas con muy buenas, ya que sufría mucho de defensas bajas y cada vez me enfermaba de resfriado. Solo hay que ser frecuente con cada toma y seguir con un buen estilo de vida.
My sister felt great taking these supplements, overall I think they are a good multivitamin and a good brand
Why did you pick this product vs others?:The best multivitamin I have ever taken. This regulated my period. I noticed I had zero pms. I felt good and I loved taking it on an empty stomach. My period moved from 24days to 27days after I started taking this. I buy for both parents too 55+ and they love it
Great daily vitamin to take! I noticed strength in my hair and nails. Also helped with my vitamin D levels! Very easy to swallow and had no problem taking it on an empty stomach.
I got this in and it was shipped with just the bottle itself…no plastic seal around the cap. At first I was thinking there would be a pull tap seal when I take the top off…nope. I’m going to try and return the package, I’m not taking vitamins that were shipped in an unsealed bottle.edit:After contacting the company directly they got in touch with me really quickly to resolve the issue. They sent me a new bottle that was sealed and ready to go free of charge due to the incident. Customer service like this doesn’t deserve a 1 star; gladly changing my review
Amazing vitamins. A bit pricey but definitely worth it. Seen a difference in hair growth and overall health. The pills are slightly larger but they dont taste bad. It is not hard to swallow. Worth your money.
I bought this product for my dad who is getting older in age and I wanted him to start taking a multivitamin to help cover vitamins he might be missing.The tablet is small but dry, meaning there isn't a coat to help make the pill easier to swallow. If you don't have any issues swallowing pills then please disregard this but if you do have a hard time swallowing pills then I would recommend also buying a pill crusher to smash the pill into pieces and then it's alot easier to swallow that way.I spoke with my dad who has been drinking this pill for a couple of weeks now to see what he thought about it and he said he feels the same with no noticeable difference from before and now. He says he still drinks it because he knows it's important to have even if he doesn't notice a major difference.The health benefits on the label may be hard to feel it yourself because it's all internal benefits that you can't physically see. My dad says his energy level is the same and doesn't feel a boost of energy. So I'm not sure how effective it is but it's always good to have and drink. Doesn't hurt not to.I posted photos of the bottle label all around for your review so you can see if you would like it. It's always good to compare the vitamin percentages with others to see if it meets your goals.It's recommended to take this one a day with food. So my dad usually drinks a pill after having a meal.I hope this review helps you make a decision.
Frequently Asked Questions
We offer two shipping options:
Economy (5–8 business days) for $4.90, and
Standard (3–4 business days) for $7.90.
Shipping fees are calculated at checkout.
If you're not completely satisfied with your purchase, you can return it within 14 for a full refund. Please ensure the item is unused and in its original packaging.
Orders are typically processed within 1–2 business days.
We offer two shipping options:
: 5 to 8 business days
: 3 to 4 business days
Delivery times may vary slightly depending on your location and order volume.
Blog posts
View all-

Discover the Power of Shilajit for Energy Boost...
Unlock the astounding benefits of high potency Shilajit for daily energy and immune support. Learn how organic Shilajit supplements enhance vitality.
Discover the Power of Shilajit for Energy Boost...
Unlock the astounding benefits of high potency Shilajit for daily energy and immune support. Learn how organic Shilajit supplements enhance vitality.
-

Shilajit의 탁월한 효과 3가지와 강력한 면역 강화 비결
Explore the myriad benefits of Shilajit, a powerful natural supplement for energy, immunity, and overall health perfect for busy professionals seeking vitality.
Shilajit의 탁월한 효과 3가지와 강력한 면역 강화 비결
Explore the myriad benefits of Shilajit, a powerful natural supplement for energy, immunity, and overall health perfect for busy professionals seeking vitality.
-

Boost Your Well-being: 5 Reasons to Take Multi ...
Elevate your beauty and wellness routine with multi collagen. Explore its benefits for hair, skin, and nails, and discover how LifeSwitch can fit into your busy lifestyle.
Boost Your Well-being: 5 Reasons to Take Multi ...
Elevate your beauty and wellness routine with multi collagen. Explore its benefits for hair, skin, and nails, and discover how LifeSwitch can fit into your busy lifestyle.